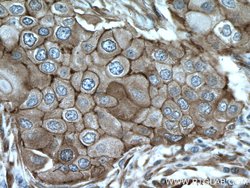
Cortactin Rabbit anti-Human, Mouse, Rat, Polyclonal, Proteintech:Antibodies:Primary

missing translation for 'onlineSavingsMsg'
Learn More
Learn More
Cortactin Rabbit anti-Human, Mouse, Rat, Polyclonal, Proteintech
Rabbit Polyclonal Antibody
€ 145.00 - € 410.00
Specifications
| Antigen | Cortactin |
|---|---|
| Concentration | 0.43 mg/mL |
| Applications | Immunoprecipitation, Immunohistochemistry (Paraffin), Immunofluorescence, Immunocytochemistry, Flow Cytometry |
| Classification | Polyclonal |
| Conjugate | Unconjugated |
| Product Code | Brand | Quantity | Price | Quantity & Availability | |||||
|---|---|---|---|---|---|---|---|---|---|
| Product Code | Brand | Quantity | Price | Quantity & Availability | |||||
|
16808423
|
Proteintech
11381-1-AP-20UL |
20 μL |
€ 145.00
20µL |
Please sign in to purchase this item. Need a web account? Register with us today! | |||||
|
16898413
|
Proteintech
11381-1-AP-150UL |
150 μL |
€ 410.00
150µL |
Please sign in to purchase this item. Need a web account? Register with us today! | |||||
Description
RSK3 is a member of the RSK (ribosomal S6 kinase) family of serine/threonine kinases. This kinase contains 2 non-identical kinase catalytic domains and phosphorylates various substrates, including members of the mitogen-activated kinase (MAPK) signalling pathway. The activity of this protein has been implicated in controlling cell growth and differentiation. Mutations in the gene have been associated with Coffin-Lowry syndrome (CLS).Specifications
| Cortactin | |
| Immunoprecipitation, Immunohistochemistry (Paraffin), Immunofluorescence, Immunocytochemistry, Flow Cytometry | |
| Unconjugated | |
| Rabbit | |
| Human, Mouse, Rat | |
| Q14247, Q60598, Q66HL2 | |
| 13043, 2017, 60465 | |
| Cortactin Fusion Protein Ag1940 | |
| Primary | |
| -20°C | |
| CTTN |
| 0.43 mg/mL | |
| Polyclonal | |
| Liquid | |
| RUO | |
| PBS with 50% glycerol and 0.1% sodium azide; pH 7.3 | |
| Amplaxin, cortactin, CTTN, EMS1, Oncogene EMS1, Src substrate cortactin | |
| Cttn | |
| IgG | |
| Antigen Affinity Chromatography | |
| Antibody |
Individuate un'opportunità di miglioramento?Condividi una correzione di contenuto
Correzione del contenuto del prodotto
Fornite il vostro feedback sul contenuto del prodotto compilando il modulo sottostante.
Titolo del prodotto